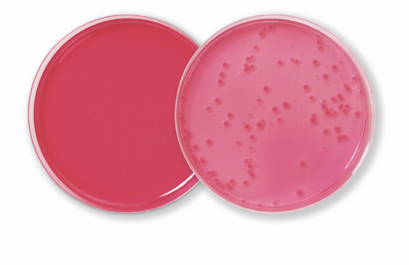

Descriere
Pata bacteriană a tomatelor este cauzată de bacteria Pseudomonas syringae pv. tomato (Pst). Bacteria poate fi introdusă prin utilizarea semințelor contaminate cu Pst. Prin urmare, detectarea Pst în semințele de tomate este comună. Pentru detectarea Pst, semințele sunt mai întâi înmuiate în tampon. Apoi, se folosește un stomacher pentru eliberarea bacteriilor din semințe. Bacteriile sunt concentrate prin centrifugare. Apoi se efectuează o însămânțare prin diluție pe două medii semi-selective KBZ și KBBC. Coloniile suspecte sunt transferate pe KB și în final identificate prin PCR sau un test de patogenitate. Pst formează colonii mici, plate și de culoare roz pe KBZ după aproximativ 5 zile. Pentru informații detaliate despre mediile fitopatologice ale Duchefa, consultați broșura noastră specializată pe acest subiect. Broșura poate fi găsită în secțiunea „Broșuri” de pe pagina principală a acestui site.